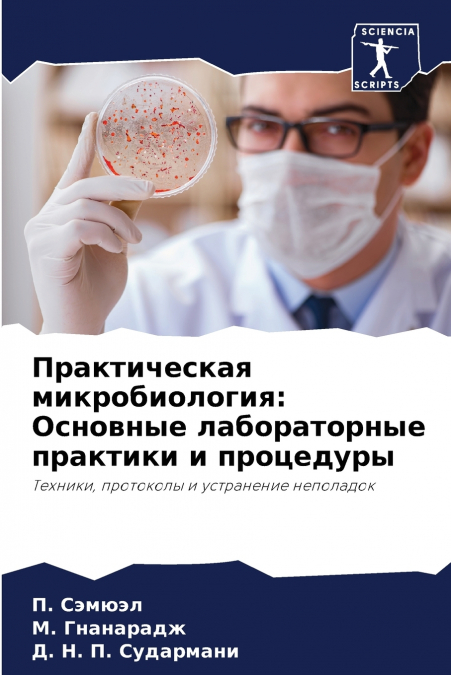
Практическая микробиология

–Ē. –Ě. –ü. –°—É–ī–į—Ä–ľ–į–Ĺ–ł / –ú. –ď–Ĺ–į–Ĺ–į—Ä–į–ī–∂ / –ü. –°—ć–ľ—é—ć–Ľ
 Librería Desdémona
Librería Desdémona
 Librería Samer Atenea
Librería Samer Atenea
 Librería Aciertas (Toledo)
Librería Aciertas (Toledo)
 K√°lamo Books
K√°lamo Books
 Librería Perelló (Valencia)
Librería Perelló (Valencia)
 Librería Elías (Asturias)
Librería Elías (Asturias)
 Donde los libros
Donde los libros
 Librería Kolima (Madrid)
Librería Kolima (Madrid)
 Librería Proteo (Málaga)
Librería Proteo (Málaga)
–ö–Ĺ–ł–≥–į '–ü—Ä–į–ļ—ā–ł—á–Ķ—Ā–ļ–į—Ź –ľ–ł–ļ—Ä–ĺ–Ī–ł–ĺ–Ľ–ĺ–≥–ł—Ź: –ĺ—Ā–Ĺ–ĺ–≤–Ĺ—č–Ķ –Ľ–į–Ī–ĺ—Ä–į—ā–ĺ—Ä–Ĺ—č–Ķ –Ņ—Ä–į–ļ—ā–ł–ļ–ł –ł –Ņ—Ä–ĺ—Ü–Ķ–ī—É—Ä—č - –ľ–Ķ—ā–ĺ–ī—č, –Ņ—Ä–ĺ—ā–ĺ–ļ–ĺ–Ľ—č –ł —É—Ā—ā—Ä–į–Ĺ–Ķ–Ĺ–ł–Ķ –Ĺ–Ķ–Ņ–ĺ–Ľ–į–ī–ĺ–ļ' —ā—Č–į—ā–Ķ–Ľ—Ć–Ĺ–ĺ —Ä–į–∑—Ä–į–Ī–ĺ—ā–į–Ĺ–ĺ –ī–Ľ—Ź —É–ī–ĺ–≤–Ľ–Ķ—ā–≤–ĺ—Ä–Ķ–Ĺ–ł—Ź –Ņ–ĺ—ā—Ä–Ķ–Ī–Ĺ–ĺ—Ā—ā–Ķ–Ļ —Ā—ā—É–ī–Ķ–Ĺ—ā–ĺ–≤ –Ņ–Ķ—Ä–≤–ĺ–≥–ĺ –ļ—É—Ä—Ā–į, –ł–∑—É—á–į—é—Č–ł—Ö –ľ–ł–ļ—Ä–ĺ–Ī–ł–ĺ–Ľ–ĺ–≥–ł—é –ł –Ī–ł–ĺ—ā–Ķ—Ö–Ĺ–ĺ–Ľ–ĺ–≥–ł—é, –≤ —Ā–ĺ–ĺ—ā–≤–Ķ—ā—Ā—ā–≤–ł–ł —Ā —É—á–Ķ–Ī–Ĺ—č–ľ –Ņ–Ľ–į–Ĺ–ĺ–ľ, —Ä–į–∑—Ä–į–Ī–ĺ—ā–į–Ĺ–Ĺ—č–ľ TANSCHE. –í —ć—ā–ĺ–ľ –Ņ–ĺ—Ā–ĺ–Ī–ł–ł –Ņ–ĺ–ī—Ä–ĺ–Ī–Ĺ–ĺ —Ä–į—Ā—Ā–ľ–į—ā—Ä–ł–≤–į—é—ā—Ā—Ź –Ľ–į–Ī–ĺ—Ä–į—ā–ĺ—Ä–Ĺ—č–Ķ –Ņ—Ä–ĺ—Ü–Ķ–ī—É—Ä—č –Ņ–ĺ –ľ–ł–ļ—Ä–ĺ–Ī–ł–ĺ–Ľ–ĺ–≥–ł–ł, –į —Ā—ā—É–ī–Ķ–Ĺ—ā—č –Ņ–ĺ–Ľ—É—á–į—é—ā –Ī–į–∑–ĺ–≤—č–Ķ –∑–Ĺ–į–Ĺ–ł—Ź –ł –Ņ—Ä–į–ļ—ā–ł—á–Ķ—Ā–ļ–ł–Ķ –Ĺ–į–≤—č–ļ–ł, –Ĺ–Ķ–ĺ–Ī—Ö–ĺ–ī–ł–ľ—č–Ķ –ī–Ľ—Ź —É—Ā–Ņ–Ķ—ą–Ĺ–ĺ–Ļ —Ä–į–Ī–ĺ—ā—č –≤ —ć—ā–ĺ–Ļ –ĺ–Ī–Ľ–į—Ā—ā–ł. –ö–Ĺ–ł–≥–į, —Ä–į–∑—Ä–į–Ī–ĺ—ā–į–Ĺ–Ĺ–į—Ź –ļ–į–ļ —É–ī–ĺ–Ī–Ĺ—č–Ļ –ī–Ľ—Ź –Ņ–ĺ–Ľ—Ć–∑–ĺ–≤–į—ā–Ķ–Ľ—Ź —Ä–Ķ—Ā—É—Ä—Ā, –ĺ—Ö–≤–į—ā—č–≤–į–Ķ—ā —ą–ł—Ä–ĺ–ļ–ł–Ļ —Ā–Ņ–Ķ–ļ—ā—Ä —ā–Ķ–ľ, –≤–ļ–Ľ—é—á–į—Ź –ľ–Ķ—ā–ĺ–ī—č –ļ—É–Ľ—Ć—ā–ł–≤–ł—Ä–ĺ–≤–į–Ĺ–ł—Ź –ľ–ł–ļ—Ä–ĺ–ĺ—Ä–≥–į–Ĺ–ł–∑–ľ–ĺ–≤, –ľ–Ķ—ā–ĺ–ī—č –ĺ–ļ—Ä–į—ą–ł–≤–į–Ĺ–ł—Ź –ł –Ī–ł–ĺ—Ö–ł–ľ–ł—á–Ķ—Ā–ļ–ł–Ķ —ā–Ķ—Ā—ā—č. –ö–į–∂–ī–į—Ź –Ņ—Ä–ĺ—Ü–Ķ–ī—É—Ä–į –Ņ—Ä–Ķ–ī—Ā—ā–į–≤–Ľ–Ķ–Ĺ–į –≤ —á–Ķ—ā–ļ–ĺ–Ļ –ł –Ľ–į–ļ–ĺ–Ĺ–ł—á–Ĺ–ĺ–Ļ –ľ–į–Ĺ–Ķ—Ä–Ķ, —Ā–ĺ–Ņ—Ä–ĺ–≤–ĺ–∂–ī–į–Ķ—ā—Ā—Ź –Ņ–ĺ—ą–į–≥–ĺ–≤—č–ľ–ł –ł–Ĺ—Ā—ā—Ä—É–ļ—Ü–ł—Ź–ľ–ł –ł –ł–Ľ–Ľ—é—Ā—ā—Ä–į—Ü–ł—Ź–ľ–ł, –ĺ–Ī–Ľ–Ķ–≥—á–į—é—Č–ł–ľ–ł –Ņ–ĺ–Ĺ–ł–ľ–į–Ĺ–ł–Ķ –ł –≤—č–Ņ–ĺ–Ľ–Ĺ–Ķ–Ĺ–ł–Ķ. –£–ī–Ķ–Ľ—Ź—Ź –ĺ—Ā–ĺ–Ī–ĺ–Ķ –≤–Ĺ–ł–ľ–į–Ĺ–ł–Ķ –Ņ—Ä–į–ļ—ā–ł—á–Ķ—Ā–ļ–ĺ–ľ—É –ĺ–Ī—É—á–Ķ–Ĺ–ł—é, —ć—ā–į –ļ–Ĺ–ł–≥–į —Ā—ā–į–Ĺ–Ķ—ā –Ĺ–Ķ–∑–į–ľ–Ķ–Ĺ–ł–ľ—č–ľ –Ņ–ĺ–ľ–ĺ—Č–Ĺ–ł–ļ–ĺ–ľ –ī–Ľ—Ź —Ā—ā—É–ī–Ķ–Ĺ—ā–ĺ–≤, –Ĺ–į—á–ł–Ĺ–į—é—Č–ł—Ö —Ā–≤–ĺ–Ļ –Ņ—É—ā—Ć –≤ —É–≤–Ľ–Ķ–ļ–į—ā–Ķ–Ľ—Ć–Ĺ—č–Ļ –ľ–ł—Ä –ľ–ł–ļ—Ä–ĺ–Ī–ł–ĺ–Ľ–ĺ–≥–ł–ł.